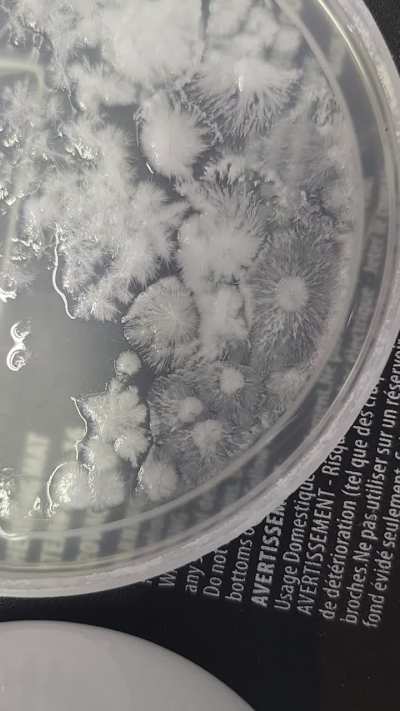

chemicalreactiongifs
chemicalreactiongifs
Browse Other Categories
- Actrezz_Hub
- ChainMailDress
- cork
- CristinaVee
- FPLmeme
- fuckwiththemomhood
- Goremovies
- GraceTrotter
- hellsingabridged
- jettalivestreams
- lapfoxtrax
- MasqueradeRepacks
- MeghaGuptaFap
- MillieBobbyWorship
- MMA_NSFW
- Shogi_Ayumu
- TheTributeHub
- TruthLeaks
- u_Cmoney1593
- u_Inastindu
- u_poop123hi
- u_rockomotion
- wmafs
- wroclaw
- xyzhate




![[OC] molecular dynamics - Xe atom vs. B12 molecule](https://img.reddit.tube/thumbnails/c693444f908fe64ed3b50ca4249f50e94b519db4.jpg?v=19700101120000)

















